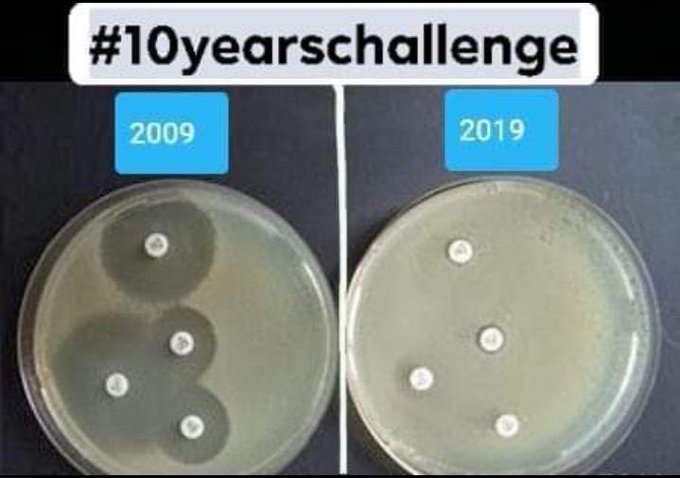

די עם אנטיביוטיקה!!!
כמות המתים מחיידקים עמידים בארץ ובעולם
אחד המקומות הכי מסוכנים לאנשים שאינם בריאים, באופן מאוד אירוני, הוא בתי החולים.
זה לא סוד שמתים בבתי חולים בישראל אלפי אנשים בישראל מדי שנה והמספרים שדיווחו עד לא מזמן 4000-6000 הם לא באמת הנתונים האמיתיים. כך נחשף דו"ח של משרד הבריאות שהראה שב-2018 מתו 13,500 אנשים.
בתוך ארבע שנים בלבד זינק בעשרה אחוזים מספר החולים שנפגעו או מתו בבתי חולים, כתוצאה מחיידקים עמידים לאנטיביוטיקה. דו"ח של משרד הבריאות חושף שב־2018 עמד מספרם על כ־13.5 אלף. יו"ר עמותת "רפואה בטוחה": "הזיהומים הפכו לגורם המוות השלישי בשכיחותו בישראל"
נכון להיום לפי ה- CDC יותר מ-35,000 אנשים מתים בארצות הברית מחיידקים עמידים לאנטיביוטיקה כל שנה.
לפי האיחוד האירופי יותר מ -35,000 אנשים מתים במדינות האיחוד מחיידקים עמידים לאנטיביוטיקה כל שנה.
נכון ל-2019 מתו 700,000 אנשים במחיידקים עמידים בעולם
הצפי ל- 30 השנים הבאות מדבר על עליה של מאות אחוזים ומוות של 10 מיליון איש כל שנה בעולם.
*** עדכון ינואר 22 ***
מחקר חדש שפורסם בינואר 22 בג'ורנל The Lancet. זהו המחקר המקיף ביותר על הנטל העולמי של זיהומים עמידים לאנטיביוטיקה (AMR) שנערך אי פעם. על פי המחקר, AMR היווה חלק מכ-4.95 מיליון מקרי מוות והיה אחראי ישירות לכ-1.27 מיליון מקרי מוות בשנת 2019. זאת בהשוואה ל-860,000 ו-640,000 מקרי מוות בהתאמה מ-HIV/איידס וממלריה באותה שנה.
עוד מצא המחקר שאחד מכל חמישה ממקרי המוות התרחש בילדים מתחת לגיל חמש.
מומחים טוענים כי סביר להניח שהמגיפה גם החמירה את הבעיה עקב חולי קוביד-19 שקיבלו אנטיביוטיקה עבור זיהומים חיידקיים משניים.
experts say the pandemic is also likely to have exacerbated the problem due to COVID-19 patients receiving antibiotics for secondary bacterial infections
https://www.news-medical.net/news/20220122/Antimicrobial-resistance-causes-more-deaths-than-HIV-and-malaria.aspx
שימוש עודף ולא נחוץ של אנטיביוטיקה
במאמר "אנטיביוטיקה – שימוש יתר, זיהום עולמי ויצירת חיידקים עמידים" אני מציג את שימוש היתר באנטיביוטיקה כחלק מטיפול ומניעה של זיהומים הם באנשים והן בתעשיית המזון מהחי.
מאמר אחר מדבר על התרומה של רופאי השיניים לשימוש העודף באנטיביוטיקה
ההשפעה המדרדרת של אנטיביוטיקה על חיידקים
התמונה שלמטה צולמה על ידי רופאה בשם kate flavin במסגרת הפרויקט של צילומי 2009 לעומת 2019. היא לא בחרה לצלם את עצמה, אלא את אחת הבעיות המטרידות ביותר בעידן הנוכחי את: עמידות החיידקים לאנטיביוטיקה!!!
וזה גם ימשיך לעלות כל זמן שיתעסקו ברפואה המנוגדת לחוקי הטבע… כל זמן שימשיכו לזהם את העולם באנטיביוטיקה מגוון החיידקים שיהיו עמידים לאנטיביוטיקה ימשיך לעלות.
העברת הגנים העמידים לאנטיביוטיקה
במחקר שפורסם באפריל 2020 בג'ורנל הרפואי eLife בדקו מגוון גדול (יותר מ-2000) של חיידקים מחוללי מחלות בבית חולים אחר למשך 18 חודשים והם ראו איך חיידקים מעבירים את החומר התורשתי שמגן עליהם מפני אנטיביוטיקה. כמו כן הם מדגישים שלא רק שרה קורה כל הזמן זהו תהליך מורכב ומאתגר עבורנו עם היכולות הנוכחיות שברשותנו.
The findings add to our understanding of how this exchange of genetic material, also known as horizontal gene transfer, happens in bacteria that cause infections in hospitals. They also highlight that while this transfer is likely to happen frequently, it is a complex process and challenging to study with current methods.

מי שימשיך לקרוא את המחקר יראה שלא רק שאין להם מושג איך להתמודד עם הבעיה הזו, אלא הם ממשיכים לסרב להכיר בעובדה שהם לא יכולים על הטבע והם ימשיכו לחפש את הדרכים לנהל את המצב.. וגם אם ימצאו משהו, הרי שעוד כמה עשורים הם יראו שהחיידקים יצליחו להסתגל לכל מצב כי הם חלק מהאקולוגיה וכך צריך להתייחס אליהם… ועד שלא יבינו אנשים תמימים ימשיכו להגיע לבתי החולים, ימשיכו לצרוך אנטיביוטיקה וימשיכו להפגע ולמות.
*** תוספת אפריל 21
במחקר שפורסם באפריל 21 בג'ורנל Cell Host & Microbe חוקרים מהמחלקה לביולוגיה של אוניברסיטת קופנהגן ניתחו דגימות צואה של 662 ילדים דנים בגיל שנה.
בתוך הדגימות גילו החוקרים 409 גנים שונים, המספקים לחיידקים עמידות בפני 34 סוגי אנטיביוטיקה. יתר על כן, 167 מתוך 409 הגנים שנמצאו עמידים בפני סוגים רבים של אנטיביוטיקה, כולל אלה המסווגים כ"חשובים קריטית "על ידי ארגון הבריאות העולמי על היכולת לטפל במחלות קשות בעתיד.
החוקרים כתבו:
זו קריאת השכמה שילדים בני שנה כבר נושאים חיידקי מעיים העמידים בפני סוגים רבים מאוד של אנטיביוטיקה.
החוקרים מצאו ששימוש באנטיביוטיקה במהלך ההריון הוא גורם עיקרי להימצאות גנים עמידים לאנטיביוטיקה וכמובן אם קיבל התינוק אנטיביוטיקה ישירות..
החוקרים מסבירים שהימצאות של חיידקים אלה בגיל כה צעיר הוא מסוכן כי גם חיידקים שקיימים באופן שוטף במעיים של תינוקות ועל פי רוב לא עושים בעיות, באיזה שהוא שלב הופכים גם הם לעמידים ומשמשים כמקור הפצה נרחב ביותר לשאר חיידקים במעיים. החוקרים הזכירו את חיידק ה- E. coli שנמצא "אספן" ראשי ומפיץ פוטנציאלי של גנים עמידים לאנטיביוטיקה לחיידקי מעיים אחרים.
החוקרים מציינים שיש קשר בין ריכוז החיידקים הטובים שנפגעים מאנטיביוטיקה לריכוז גבוה יותר של חיידקים עמידים ושמחקרים קודמים מאותה קבוצת ילדים הראו שהתפתחות זו של פלורת המעיים קשורה לסיכון לאסתמה בשלב מאוחר יותר בחיים.לצערי גם החוקרים האלה לא הבינו עדין את המסר וגם הם כנראה לא ישקימו קום. הם עדין לא יפסיקו לתת אנטיביוטיקה בהריון והם רק יחפשו דרכים לסלק/לחסל את החיידקים מפיצי הגנים.
The new knowledge brought about by this study may prove useful in the effort to better manage antibiotic treatments among pregnant women and serve as a basis for more targeted methods of eliminating the types of bacteria which collect resistance genes
https://science.ku.dk/english/press/news/2021/hundreds-of-antibiotic-resistant-genes-found-in-the-gastrointestinal-tracts-of-danish-infants/?fbclid=IwAR3lte2-4h05kkCeiLzPXsrnV9GaF6zKNJMEzeG7dyesLE0VM-PyWIuU_O0
ולכן אם היו משנים גישה היה ניתן להוריד בדרך הטבע גם בבתי חולים את כמות הפתוגנים במעל 95% על ידי שימוש במשטחים של נחושת ו/או גרפיט… והיה ניתן גם להעזר בתכשירים אחרים שאינם גורמים נזק והם חלק מהאקולוגיה ותורמים למערכת החיסון שלנו בלי לפגוע במיקרוביום.
נזקים ידועים נוספים של אנטיביוטיקה ותרומתם למחלות:
נמצא קשר בין שימוש מוקדם של אנטיביוטיקה למחלות אקוטיות וכרוניות רבות
אנטיביוטיקה היא התרופה שמשפיעה יותר מכל התרופות על שינוי המיקרוביום לרעה ולכך השלכות בכל היבט בריאותי: מערכת חיסון, מצבים נפשיים ונוירולוגיים (Gut-Brain-Axis).
אנטיביוטיקה מעלה סיכון להישנות המחלה, הפניות למיון ואשפוזים.
אנטיביוטיקה מעלה סיכון לחלות בשפעת.
חשיפה מוקדמת לאנטיביוטיקה עלולה לגרום לאסתמה ואלרגיות קבועות.
אנטיביוטיקה – דלקות חוזרות בדרכי השתן (UTI).
אנטיביוטיקה – תסמונת המעי הרגיז וסרטן המעי הגס.
אנטיביוטיקה בהריון ובינקות – קרוהן וקוליטיס.
אנטיביוטיקה ודלקות פרקים.
אנטיביוטיקה גורם סיכון לצליאק.
הקשר שבין אנטיביוטיקה ל-ADHD.
אנטיביוטיקה בגילאים צעירים מפחיתה את ביטוי הקולטנים של אנדורפין, אוקסיטוצין וואסופרסין בקליפת המוח הקדמית.
אנטיביוטיקות נפוצות גורמות לפרקינסון.
אנטיביוטיקה – נוירוטוקסין.
אנטיביוטיקה ולחץ דם גבוה.
נשים המשתמשות בכמות משמעותית של אנטיביוטיקה נוטות יותר לסבול מירידה קוגניטיבית בשלב מאוחר יותר.
אנטיביוטיקה – שימוש יתר, זיהום עולמי ויצירת חיידקים עמידים ופטריות מסכנות חיים.
אמא שלוקחת אנטיביוטיקה מעלה סיכון לחשיפת חיידקים עמידים אצל הילדים שלה.
האחריות חייבת לעבור אל ההורים כי מהרופאים ומהממסד לא נראה שינוי – אין להם כלי אחר!
חשוב להבין שלכל דבר יש סיבה ולכל דבר יש פתרון מהטבע ומבלי לפגוע במשהו אחר.
אין שום סיבה לקחת אנטיביוטיקה אלא רק אם נמצאים בסכנת חיים ממשית ואקוטית!
היי לך.. אני משקיע שעות רבות כל יום באיתור ותרגום מאמרים כדי לספק לכולם את המידע העדכני ביותר, לבריאות טובה בדרך הטבע. וכדי שאוכל להמשיך לספק את המידע ולתחזק את האתר. כל תרומה, גדולה או קטנה תהיה לעזר רב. לתרומה נוחה ופשוטה דרך Pay Pal.
מוזמנים להזין דוא"ל למטה כדי להתעדכן ראשונים





כתיבת תגובה